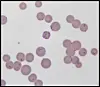

EPIDEMI I DANMARK: Mycoplasmabakterien spres i Danmark. Foto: Wikimedia Commons
Danske helsemyndigheter erklærer Mycoplasma-epidemi
Økningen i antall luftveisinfeksjoner med Mycoplasma pneumoniae har nådd epidemisk nivå, opplyser Statens Serum Institut i Danmark.
Denne artikkelen er mer enn to år gammel.
DM Pluss for helsepersonell
0 kr
Gratis for helsepersonell ved å oppgi HPR-nummer.
Registrer deg
DM Pluss
49 kr
for de første 30 dagene, deretter 417 kr (eks. MVA) per måned. Ett års bindingstid. Oppsigelse mulig i prøveperiode. Betal via kort og Vipps.
Registrer deg
Bedriftsabonnement
Ta kontakt med oss så skreddersyr vi løsning for deg og din bedrift.
Les mer